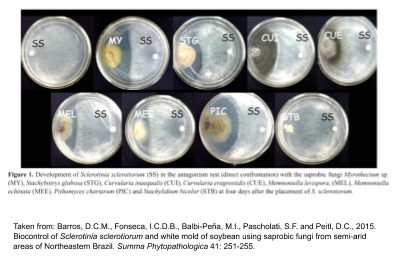

Knowledge Hub
Extension Articles

Sclerotinia rot of cabbage
Cabbage is a susceptible host crop of Sclerotinia sclerotiorum and infection can result in devastating losses for producers.
SclerotiniaZA Pamphlet Continued
This pamphlet was created in 2019 to be shared at Information Days.
SclerotiniaZA Pamphlet
This pamphlet was created in 2019 to be shared at Information Days.
sclerotiorum and rolfsii
Diagnostics 101: signs of the pathogen
Sclerotia - the survival of Sclerotinia sclerotiorum
Diagnostics 101: a brief overview of the overwintering strategy of Sclerotinia sclerotiorum
Alternative hosts associated with Sclerotinia sclerotiorum - weeds
Identifying weed hosts associated with Sclerotinia sclerotiorum
Sclerotinia culture collection
The official Sclerotinia sclerotiorum culture collection, housed at the University of the Free State, provides local S. sclerotiorum isolate access and availability to researchers.
Weed hosts associated with Sclerotinia sclerotiorum
A short introduction to the weed hosts associated with Sclerotinia sclerotiorum, which serve as inoculum reservoirs and potential sites for overwintering.
Sclerotinia sclerotiorum diagnostics rolfsii
Diagnostics 101: signs of the pathogen
Sclerotinia sclerotiorum diagnostics
Diagnostics 101: signs of the pathogen
Biological control of Sclerotinia diseases associated with oilseed crops
Biological control associated with protecting oilseed crops from Sclerotinia diseases, an article originally written for the Oilseed Focus Magazine, Jan 2020.
Chemical control of Sclerotinia diseases: a fungicide-resistance minded approach.
A brief summary of chemical control available for Sclerotinia diseases and protecting our active ingredients.
South African Sclerotinia sclerotiorum research in the age of genomics

Monitoring of Sclerotinia Stem Rot of Canola in the Western Cape province of South Africa
A review on the Western Cape Department of Agriculture, Directorate Plant Sciences, Plant Pathology monitoring strategies for Sclerotinia stem rot of canola.
Management of Sclerotinia head and stem rot
A link to an article written for GrainSA on the management of Sclerotinia diseases.
Sclerotinia sclerotiorum: An in field life cycle on sunflower.
A photographic illustration of the in-field life cycle of Sclerotinia sclerotiorum, the fungal pathogen responsible for causing sunflower head and stem rot.
Sclerotinia sclerotiorum: An in field life cycle on soybean.
A photographic illustration of the in-field life cycle of Sclerotinia sclerotiorum, the fungal pathogen responsible for causing soybean stem rot.
Development of novel risk reduction strategies Sclerotinia head and stem rot
Written for the Oilseed Focus Magazine June 2019
Sclerotinia sclerotiorum population dynamics - a force to be reckoned with.
Written for the Oilseed Focus Magazine September 2019EXTENSION ARTICLES
Thank you to the active members who contribute to popular extension articles for our local producers and industry members. If you are interested in submitting an article feel free to contact info@sclerotinia.co.za
Sclerotinia rot of cabbage SclerotiniaZA Pamphlet Continued SclerotiniaZA Pamphlet sclerotiorum and rolfsii Sclerotia - the survival of Sclerotinia sclerotiorum Alternative hosts associated with Sclerotinia sclerotiorum - weeds Sclerotinia culture collection Weed hosts associated with Sclerotinia sclerotiorum Sclerotinia sclerotiorum diagnostics rolfsii Sclerotinia sclerotiorum diagnostics Biological control of Sclerotinia diseases associated with oilseed crops Chemical control of Sclerotinia diseases: a fungicide-resistance minded approach. South African Sclerotinia sclerotiorum research in the age of genomics Monitoring of Sclerotinia Stem Rot of Canola in the Western Cape province of South Africa Management of Sclerotinia head and stem rot Sclerotinia sclerotiorum: An in field life cycle on sunflower. Sclerotinia sclerotiorum: An in field life cycle on soybean. Development of novel risk reduction strategies Sclerotinia head and stem rot Sclerotinia sclerotiorum population dynamics - a force to be reckoned with.